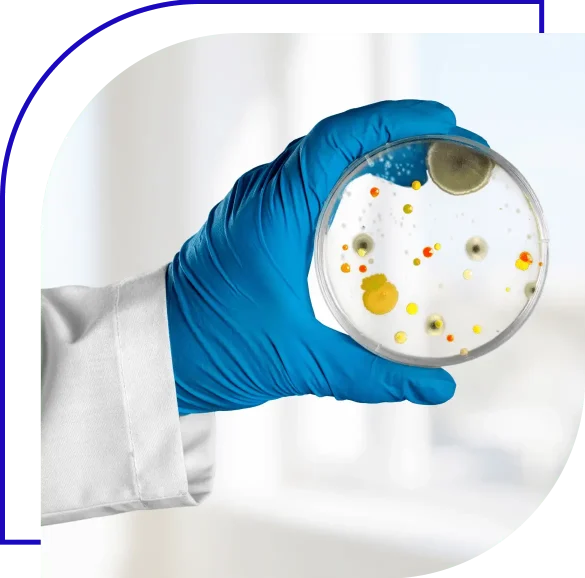
pathogen

IEH Academy Webinar
Essentials of Finished Product Pathogen Sampling and Testing
Dr. Donald Zink and Dr. Gene Bartholomew hosted a live webinar to discuss the importance of in-process and finished product testing as a verification tool for food safety programs.
- July 26th, 2022
- 11:00 AM -12:00 PM PST / 2:00 PM - 3:00 PM EST
- Dr. Donald Zink, Dr. Gene Bartholomew
Webinar Description
Virtually all food processors and manufacturers conduct sampling and testing of finished products prior to shipment, and many tests in process material as well. The webinar will primarily discuss presence-absence testing for pathogens and allergens. Customers often require finished product testing and, in some cases, these test requirements may be unreasonable or ineffective. We will discuss strategies for developing effective specifications with suppliers and customers.
Topics Covered
- Designing a sampling plan
- Choosing a test method
- Response to a positive result
- Carving out implicated products
- Regulatory environment related to finished product testing
- Reportable registry
- Corrective actions

-
President of Food & Regulatory Compliance
IEH Laboratories & Consulting Group
Meet the Instructor
Dr. Donald Zink

-
Vice President, Technical Services
IEH Laboratories & Consulting Group
Meet the Instructor
Dr. Gene Bartholomew
Let's get in touch
Have questions? Our team is here to help. Also available is IEH customer service at (206)522-5432 or iehacademy@iehinc.com. By filling out this information, you are adhering to our privacy policy.